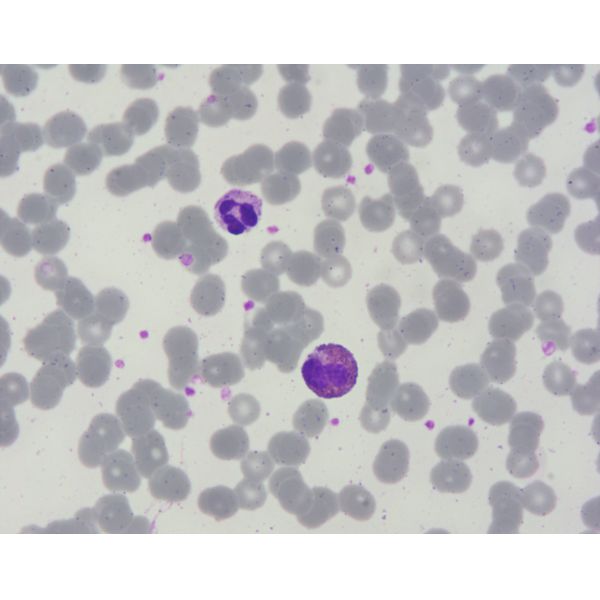

| Sign In | Join Free | My insurersguide.com |
|
| Sign In | Join Free | My insurersguide.com |
|
| Categories | Cytology Stains |
|---|---|
| Brand Name: | Baso |
| Model Number: | 4×250mL; 3×100mL; 6×20mL |
| Certification: | IVDR Class A; ISO 13485:2016 |
| Place of Origin: | China |
| MOQ: | 1 Box |
| Price: | Negotiated |
| Payment Terms: | T/T |
| Delivery Time: | To be confirmed |
| Packaging Details: | Paper box |
| Supply Ability: | To be confirmed |
| Company Info. |
| Baso Group |
| Verified Supplier |
| View Contact Details |
| Product List |
What is Liu's Stain?
Mainly used for blood cell smears, bone marrow smears, vaginal discharge (gynecological leucorrhea) smears, exfoliated cell smears staining. Liu’ s Stain is modified from the Romanowsky Stain technique. Staining of cells involves physical adsorption and chemical affinity which allows stain to penetrate and remain within cells. Because each cell and its components are different in chemical composition, their affinity to acid stain (Eosin) and alkaline stain (Methylene blue) of this kit varies significantly. After staining the smear with the Liu’ s Stain, different types of cells will appear in different colors. Consequently, one can identify cells based on their stain color, shape and other physical characteristics.
Staining Results
Blood cell smear, bone marrow smear staining: The red blood cells are light red, and the particles in the white blood cell paste are clear, and they show various colors unique to the cells. The nucleus is purple, and the nuclear chromatin structure is clear.
Order Information
Product Name | Ref # | Specification |
Liu's Stain | BA4000 | 4×250mL |
Liu's Stain | BA4007 | 3×100mL |
Liu's Stain | BA4031 | 6×20mL |
Liu's Stain - A Solution | BA4001 | 4×250mL |
Liu's Stain - B Solution | BA4002 | 4×250mL |

|